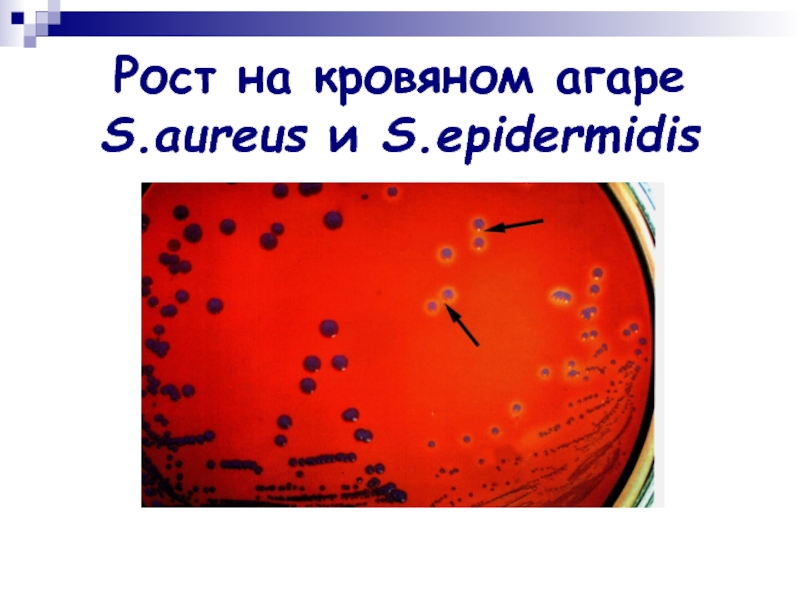
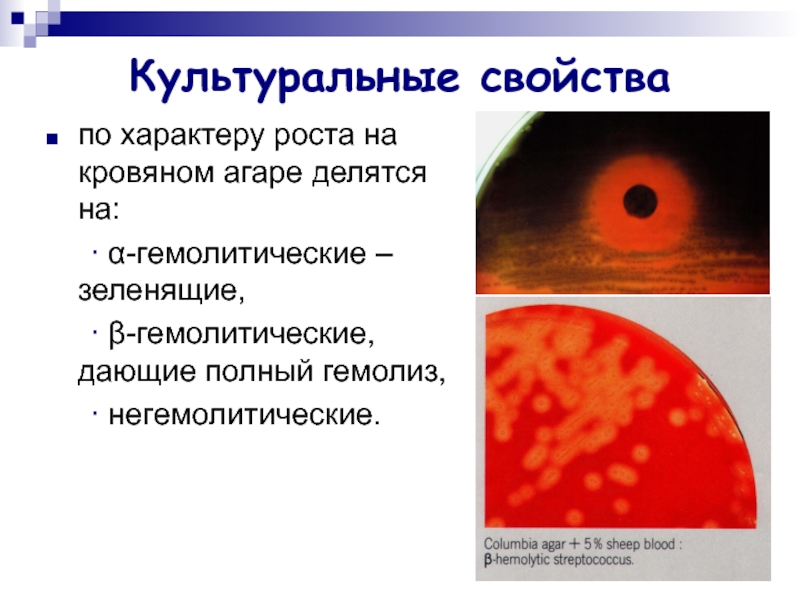

Разделы презентаций
- Разное
- Английский язык
- Астрономия
- Алгебра
- Биология
- География
- Геометрия
- Детские презентации
- Информатика
- История
- Литература
- Математика
- Медицина
- Менеджмент
- Музыка
- МХК
- Немецкий язык
- ОБЖ
- Обществознание
- Окружающий мир
- Педагогика
- Русский язык
- Технология
- Физика
- Философия
- Химия
- Шаблоны, картинки для презентаций
- Экология
- Экономика
- Юриспруденция
ПАТОГЕННЫЕ КОККИ
Содержание
- 1. ПАТОГЕННЫЕ КОККИ
- 2. ПАТОГЕННЫЕ КОККИПатогенные и условно-патогенные. Строгие анаэробы (пептококки,
- 3. ОБЩАЯ ХАРАКТЕРИСТИКА ПАТОГЕННЫХ КОККОВ
- 4. Слайд 4
- 5. Грамположительные коккиСтафилококкиСтрептококки
- 6. Стафилококки
- 7. ТаксономияPhylum BXIII. Firmicutes Class III. "Bacilli"
- 8. Морфологияокруглые клетки диаметром 0,5-1 мкм; «гроздья винограда»плазмиды
- 9. Тинкториальные свойстваГрамположительны
- 10. Культуральные свойствафакультативные анаэробы (хемоорганотрофы с окислительным и
- 11. Рост на кровяном агаре S.aureus и S.epidermidis
- 12. Ферментативные свойствабиохимически активны: ферментируют с выделением кислоты
- 13. Патогенностьадгезия: тейхоевые кислоты, капсульные полисахариды;капсула: индукция цитокинов
- 14. Токсины стафилококковэксфолиативные токсины А и В –
- 15. Антигенные свойстваоколо 30 АГ: белки, полисахариды и
- 16. ПатогенезИсточник стафилококковой инфекции – человек, животные (больные
- 17. Клиническое разнообразиеспособность стафилококка вызывать пиогенную инвазию кожи
- 18. Клиническое разнообразиеОколо 120 клинических форм гнойно-воспалительные болезни
- 19. Наиболее поражаемые органы. Практически все органы.Выведение возбудителя
- 20. Микробиологическая диагностикаМатериал: гнойное отделяемое, кровь, спинно-мозговая жидкость,
- 21. Лечение и профилактикаантибиотики; антитоксическая стафилококковая плазма или
- 22. Стрептококки
- 23. ТаксономияFamily VI. Streptococcaceae Genus I. Streptococcus Species. S.pyogenes, S.pneumonia, S.agalactia, S.mutans, S.mitis, S. salivarium
- 24. Классификация стрептококковПо культуральным признакам.По гемолитической активности:
- 25. Стрептококки группы А: S.pyogenes S.pneumonia
- 26. Streptococcus pyogenes
- 27. Морфологиямелкие (0,5-2 мкм) шаровидные клетки; располагаются цепочками
- 28. Тинкториальные свойстваграмположительные
- 29. Культуральные свойстваСтрептококки – факультативные анаэробы, растут на
- 30. Культуральные свойствапо характеру роста на кровяном агаре
- 31. Ферментативные свойстваS. pyogenes ферментирует глюкозу, мальтозу, лактозу,
- 32. Антигенные свойстваПолисахаридный АГ – «субстанция С» (по
- 33. ПатогенностьАдгезия – капсульные полисахариды, М- (адгезия к
- 34. ПатогенезИсточник инфекции – больной, реконвалесцент, носитель. Механизмы
- 35. Клиническое многообразиеS.pyogenes может вызывать у человека:гнойно-воспалительные процессы
- 36. СкарлатинаОстрое инфекционное заболевание, характеризующееся ангиной, общей интоксикацией,
- 37. РожаОстрое флегмоноподобное воспаление
- 38. Ревматизм, гломерулонефритМеханизмы патогенеза: ∙ перекрестные АГ
- 39. Механизмы саногенезаАнтитоксины, типоспецифические М-антитела, иммунный фагоцитоз. После перенесения скарлатины формируется напряженный антитоксический иммунитет.
- 40. Микробиологическая диагностикаМатериал : гной, слизь из зева
- 41. Микробиологическая диагностика+Вирулентность микроорганизмов определяют внутрибрюшинным введением культуры
- 42. Лечение и профилактикаЛечение антибиотиками (β-лактамы, макролиды). Стрептококковый
- 43. Пневмококки Streptococcus pneumoniaeМожет вызывать пневмонии, бронхиты, воспалительные
- 44. Морфологияланцетовидные диплококки, короткие цепочки; полисахаридная капсула; М-протеин
- 45. Тинкториальные свойстваГрамположительны
- 46. Культивированиефакультативные анаэробы;на питательных средах теряют капсулу и
- 47. Ферментативные свойстваРасщепляют до кислоты, без газа глюкозу, мальтозу, галактозу и др.Оксидазу и каталазу не продуцирует.
- 48. Антигенная структураS.pneumoniae содержит: ∙ поверхностный полисахаридный
- 49. ПатогенностьАдгезия – капсульные полисахариды, тейхоевые кислоты и
- 50. ПатогенезИсточник – больной, носитель.Механизмы заражения – аспирационный,
- 51. ИммунитетИммунитет к пневмококковой инфекции типоспецифический. Реализуется через АТ, фагоцитоз и комплемента.
- 52. Микробиологическая диагностикаМатериал: мокрота, смывы с бронхов, плевральная
- 53. Лечение и профилактикаДля лечения – антибиотики (β-лактамы,
- 54. Стрептококки группы ВS.agalactia – β-гемолитический стрептококк.Отличие от
- 55. Зеленящие стрептококки группы viridans, лишенные группоспецифического антигенаГруппа
- 56. ЭнтерококкиFamily EnterococcaceaeE.faecalis – 80-90%, E.faecium
- 57. Грамотрицательные коккиОсновное значение – Neisseria (N.meningitidis и
- 58. Нейссерии
- 59. ТаксономияFamily. Neisseriaceae Genus. Neisseria Species. N.meningitidis, N.gonorrhoeae
- 60. Менингококки Neisseria meningitidis Менингококковая инфекция –
- 61. МорфологияМелкие (0,6-0,8 мкм) диплококки. Пара бобовидных клеток,
- 62. КультивированиеМенингококки – аэробы, обладают цитохромоксидазой и каталазой.
- 63. Ферментативные свойстваМенингококки расщепляют с образованием кислоты глюкозу и мальтозу.
- 64. Антигенная структураПо капсульным АГ – серогруппы А,
- 65. ПатогенностьПили, белки наружной мембраны – адгезия;капсульные полисахариды
- 66. ПатогенезИсточник инфекции – больной или носитель (15-20%
- 67. ПатогенезВедущая роль в патогенезе тяжелых форм –
- 68. ИммунитетПостинфекционный иммунитет при генерализованных формах инфекции стойкий,
- 69. Микробиологическая диагностикаМатериал: кровь, СМЖ, носоглоточные смывы. +
- 70. Микробиологическая диагностика2. + Посев на
- 71. Лечение и профилактикаАнтибиотики (пенициллины, левомицетин, рифампицин). Специфическая
- 72. Возбудитель гонореи Neisseria gonorrhoeaeГонорея – инфекционная
- 73. МорфологияГонококк – Г «–» диплококк бобовидной формы,
- 74. КультивированиеГонококк – аэроб, требователен к питательным средам.
- 75. Ферментативные свойстваФерментирует только глюкозу, образует каталазу и цитохромоксидазу.
- 76. ПатогенностьПили: адгезия, передвижение по слизистой, образование биопленки.
- 77. ПатогенезИсточник инфекции – больной
- 78. ИммунитетИммунитет не формируется (высокая изменчивость, низкая иммуногенность
- 79. Микробиологическая диагностика+ основной: бактериоскопия препаратов гнойного отделяемого,
- 80. Лечение и профилактикаЛечение – антибиотикотерапия (β-лактамы: цефтриаксон,
- 81. Скачать презентанцию
ПАТОГЕННЫЕ КОККИПатогенные и условно-патогенные. Строгие анаэробы (пептококки, пептострептококки, вейлонеллы), факультативные анаэробы и аэробы (стрептококки, стафилококки, нейссерии). Гнойно-воспалительные болезни различной локализации и тяжести.
Слайды и текст этой презентации
Слайд 2ПАТОГЕННЫЕ КОККИ
Патогенные и условно-патогенные.
Строгие анаэробы (пептококки, пептострептококки, вейлонеллы), факультативные
анаэробы и аэробы (стрептококки, стафилококки, нейссерии).
и тяжести.Слайд 7Таксономия
Phylum BXIII. Firmicutes
Class III. "Bacilli"
Order I. Bacillales
Family V. "Staphylococcaceae"
Genus I. Staphylococcus
Species. S.aureus, S.epidermidis,
S.saprophyticus Слайд 8Морфология
округлые клетки диаметром 0,5-1 мкм;
«гроздья винограда»
плазмиды – синтез коагулазы,
гемолитических токсинов, фибринолизина, пигментов, устойчивости к антибиотикам;
спор не образуют,
жгутиков не имеют; могут образовывать капсулу, чаще полисахаридной природы.
могут образовывать L-формы.
Слайд 10Культуральные свойства
факультативные анаэробы (хемоорганотрофы с окислительным и бродильным типом метаболизма);
хорошо растут на простых средах (рН 7,0):
∙
на жидких – помутнение среды с последующим выпадением осадка, при аэрации на поверхности бульона образуется пленка; ∙ на плотных – S и R колонии с различным пигментом (золотистым, палевым, лимонно-желтым, белым);
могут расти на агаре с высоким содержанием NaCl (8-10%);
на кровяном агаре – гемолиз.
Слайд 12Ферментативные свойства
биохимически активны: ферментируют с выделением кислоты глицерин, мальтозу, сахарозу,
маннит, восстанавливают нитраты в нитриты, продуцируют уреазу, фосфатазу, аргиназу.
Глюкозу
ферментируют как в аэробных и анаэробных условиях. Выделяют сероводород и аммиак.
Оксидазоотрицательны.
Стафилококки делятся на каталазоположительные (S.aureus) и каталазоотрицательные (S. epidermidis, S. saprophyticus ).
S. epidermidis не сбраживает маннита.
S. saprophyticus не сбраживает маннозу, не продуцирует фосфатазу.
Слайд 13Патогенность
адгезия: тейхоевые кислоты, капсульные полисахариды;
капсула: индукция цитокинов → возникновение очагов
воспаления → образование абсцессов; подавление активности фагоцитов;
факторы угнетающие фагоцитоз
(белок А, пептидогликан, тейхоевые кислоты); около 30 ферментов агрессии: плазмокоагулаза, ДНКаза, лейкоцидины, лецитовителлаза, фосфатаза, бактериоцины, гемолизины α, β, γ, δ, фибринолизин, и др.
каталаза, каратиноидные пигменты – защита от оксидантов;
устойчивость к антибиотикам: R-плазмиды, β-лактамазы;
токсины.
Слайд 14Токсины стафилококков
эксфолиативные токсины А и В – суперантигены, вызывают слущивание
эпидермиса, отслойку рогового слоя и развитие синдрома ошпаренной кожи;
энтеротоксины А,
В, С, С1 С2 , D, Е – термостабильные низкомолекулярные белки, суперантигены;токсин синдрома токсического шока (раннее энтеротоксин F) - экзотоксин, характеризующийся слабой гемолитической и высокой протеолитической активностью;
β–токсин – цитотоксическое действие;
γ–токсин лизирует эритроциты;
δ–токсин обладает широким спектром цитотоксической активности.
Слайд 15Антигенные свойства
около 30 АГ: белки, полисахариды и тейхоевые кислоты.
выделяют
6 эковаров стафилококков (А, В, С, D, E, F). Эковар
А вызывает заболевания у человека, а остальные – у животных. Внутри эковара А выделяют 46 фаговаров.Чувствительность к бактериофагам является стабильной генетической характеристикой, что обусловлено поверхностными рецепторами. Многие штаммы стафилококков являются лизогенными (образование некоторых токсинов происходит с участием профага).
В составе клеточной стенки стафилококка содержится протеин А, который может прочно связываться с Fc-фрагментом молекулы Ig, (коагглютинация).
Большинство внеклеточных веществ, продуцируемых стафилококками, также обладают антигенной активностью.
Слайд 16Патогенез
Источник стафилококковой инфекции – человек, животные (больные или носители).
20%
людей не поддерживают носительства, 60% – транзиторное носительство, 20% –
длительное носительство, (эпидемически опасным считается присутствие более 10 млн. бактерий в 1 мл назального секрета).Механизм передачи – респираторный, контактно-бытовой, алиментарный.
Восприимчивость людей всеобщая.
Входные ворота – кожа, слизистые.
Резистентность ↑ – локальная инфекция; ↓ – генерализованная инфекция.
Слайд 17Клиническое разнообразие
способность стафилококка вызывать пиогенную инвазию кожи и ее придатков;
проникать
в кровь и индуцировать пиогенные (гнойно-деструктивные) поражения внутренних органов;
вызывать неспецифическую
(септическую) и специфические интоксикации.Слайд 18Клиническое разнообразие
Около 120 клинических форм гнойно-воспалительные болезни кожи и мягких
тканей (фурункулы, абсцессы, пиодермии и др.), поражения глаз, уха, носоглотки,
урогенитального тракта, пищеварительной системы (интоксикации), опорно-двигательного аппарата и других органов.Острые кишечные заболевания и менингиты стафилококки вызывают у новорожденных и детей младшего возраста.
Слайд 19Наиболее поражаемые органы. Практически все органы.
Выведение возбудителя во внешнюю среду
осуществляется с мокротой, мочой, испражнениями, гнойным отделяемым.
Механизмы саногенеза: гуморальные и
клеточные факторы (антитоксины, антимикробные антитела, фагоцитоз).Слайд 20Микробиологическая диагностика
Материал: гнойное отделяемое, кровь, спинно-мозговая жидкость, слизь из зева
и носа, мокрота, испражнения, моча, рвотные массы, промывные воды желудка,
зараженные пищевые продукты.+ ответ ориентировочный.
+ основной. Отнесение культуры к роду стафилококков основывается на типичной морфологии и окраске клеток, их взаимном расположении и анаэробной ферментации глюкозы. Для видовой идентификации используют в основном биосинтез плазмокоагулазы, лецитиназы, анаэробную ферментацию маннита и глюкозы. В сомнительных случаях ставят тесты на ДНК-азу и α-токсин. Необходимо использование количественных методов исследования.
– исключение – энтероинфекция, заражают котят. Дермонекротическую пробу проводят на кроликах.
+ при хронизации процесса (РНГА, РИФ, ИФА ).
– Тип ответа смешанный – ВТ.
Слайд 21Лечение и профилактика
антибиотики;
антитоксическая стафилококковая плазма или Ig,
нормальный донорский
Ig;
адсорбированный стафилококковый анатоксин;
вакцина стафилококковая;
бактериофаг стафилококковый.
Профилактика стафилококковых инфекций у новорожденных:
иммунизация рожениц стафилококковым анатоксином, проведение анализа на обсемененность материнского молока.Слайд 23Таксономия
Family VI. Streptococcaceae
Genus I. Streptococcus
Species. S.pyogenes, S.pneumonia,
S.agalactia, S.mutans, S.mitis, S. salivarium
Слайд 24Классификация стрептококков
По культуральным признакам.
По гемолитической активности:
∙ α-гемолитические
– дают частичный гемолиз и зеленоватое окрашивание среды;
∙ β-гемолитические – полностью гемолизирующие стрептококки;∙ γ – не гемолитические - не вызывают гемолиз.
Альфа и альфа1 стрептококки называют S. viridans – зеленящие.
Серологическая классификация Ребекки Лэнсфильд (по группоспецифическим полисахаридным АГ клеточной стенки): 20 серологических групп от А до V. Серовары – по специфическим белковым АГ.
Слайд 27Морфология
мелкие (0,5-2 мкм) шаровидные клетки;
располагаются цепочками или попарно;
спор
не образуют, неподвижны;
образуют капсулу, состоящую из гиалуроновой кислоты;
клеточная
стенка содержит белки (М,- Т- и R), углеводы и пептидогликаны; образуют L-формы.
Слайд 29Культуральные свойства
Стрептококки – факультативные анаэробы, растут на средах, обогащенных углеводами,
кровью, сывороткой, асцитической жидкостью;
на плотных питательных средах образуют колонии
трех типов:∙ мукоидные – крупные блестящие вязкой консистенции, напоминающие каплю воды (капсульные штаммы),
∙ R – штаммы, имеющие М АГ,
∙ S – невирулентные штаммы;
на жидких средах – придонно-пристеночный рост в виде крошковатого осадка.
Слайд 30Культуральные свойства
по характеру роста на кровяном агаре делятся на:
∙ α-гемолитические – зеленящие,
∙
β-гемолитические, дающие полный гемолиз,∙ негемолитические.
Слайд 31Ферментативные свойства
S. pyogenes ферментирует глюкозу, мальтозу, лактозу, сахарозу, маннит с
образованием кислоты без газа.
Расщепляет салицин, трегалозу.
Протеолитической активностью не
обладает.Слайд 32Антигенные свойства
Полисахаридный АГ – «субстанция С» (по Ленсфилд) S.pyogenes –
серогруппа А.
Белковый АГ М – типовой (свыше 100 серотипов
серогруппы А).Перекрестные АГ: АТ к ним реагируют с мышечными волокнами миокарда, тканью почки и др. → иммунопатологические состояния.
Капсула состоит из гиалуроновой кислоты идентичной обнаруживаемой в соединительной ткани человека (стрептококки не распознаются как «чужие»).
Слайд 33Патогенность
Адгезия – капсульные полисахариды, М- (адгезия к кератоцитам и подавление
фагоцитоза) и F-белки (адгезия к эпителию респираторного тракта и к
клеткам Лангерганса кожи).Инвазия: гиалуронидаза, ДНКаза, РНК-аза, АТФ-аза и др.
Стрептокиназа (фибринолизин) – растворение фибрина, генерализация.
О-стрептолизин разрушает мембраны клеток, лизосом, кардиотоксичен, АГ – анти-О-стрептолизины.
S-стрептолизин – разрушает мембраны.
Кардиогепатический токсин вызывает поражения миокарда и диафрагмы, образование гигантоклеточных гранулем в печени .
Эритрогенины (термостабильный токсин А, токсин С) – нарушают межклеточные контакты, пирогенность, действуют иммуноопосредовано вызывая образование ярко-красных кожных высыпаний.
Слайд 34Патогенез
Источник инфекции – больной, реконвалесцент, носитель.
Механизмы передачи – аспирационный,
контактный, реже алиментарный.
Пути передачи – воздушно-капельный, прямой и непрямой контакт,
пищевой.Входные ворота – миндалины, слизистые оболочки верхних дыхательных путей, поврежденная кожа, у новорожденных – пупочная ранка.
↑ резистентность –локальная инфекция, ↓ резистентность –генерализация (лимфо- и гематогенно).
Наиболее поражаемый орган – небные миндалины (тонзилит), сердечная мышца, кожа, подкожная клетчатка (рожа, скарлатина); почка (острый гломерулонефрит).
Слайд 35Клиническое многообразие
S.pyogenes может вызывать у человека:
гнойно-воспалительные процессы (ангина, абсцессы, флегмоны,
гаймориты, фронтиты, лимфадениты, циститы, пиелонефриты и др.),
ненагноительные воспалительные процессы
(рожа, стрептодермия, импетиго, скарлатина, острая ревматическая инфекция гломерулонефрит, эндокардит и др.), генерализованные формы инфекции – токсический шок, сепсис.
Слайд 36Скарлатина
Острое инфекционное заболевание, характеризующееся ангиной, общей интоксикацией, появлением точечных высыпаний
на шее и груди ярко-красного цвета (scarlatinum – красный цвет).
Скарлатинозный синдром – эритрогенный токсин.
Болеют дети от 1 года до 8 лет.
Слайд 37 Рожа
Острое флегмоноподобное воспаление кожи.
erysipelas (греч. –
красная кожа).
Инфекция распространяется в субэпителиальной ткани лица, головы, нижних
конечностей, реже других частей тела.Слайд 38Ревматизм, гломерулонефрит
Механизмы патогенеза:
∙ перекрестные АГ стрептококка,
∙
развитие гиперчувствительности
иммунокомплексного типа,
∙ длительная
персистенция L-форм стрептококков.ревматизму чаще предшествуют поражение миндалин и глотки;
гломерулонефриту – кожные формы стрептококковой инфекции.
Слайд 39Механизмы саногенеза
Антитоксины, типоспецифические М-антитела, иммунный фагоцитоз.
После перенесения скарлатины формируется
напряженный антитоксический иммунитет.
Слайд 40Микробиологическая диагностика
Материал : гной, слизь из зева и носа, моча
и др. При подозрении на сепсис – кровь.
+ ориентировочный.
+ основной. Материал засевают на кровяной агар, колонии характеризуют по характеру гемолиза, идентифицируют по антигенным свойствам в РП со специфическими сыворотками. Для дифференциации стрептококков группы А от других β-гемолитических стрептококков применяют тест чувствительности к бацитрацину (чувствительны). РИФ, ИФА, ПЦР.
Слайд 41Микробиологическая диагностика
+Вирулентность микроорганизмов определяют внутрибрюшинным введением культуры стрептококков кроликам.
+
при хронических формах, для подтверждения диагноза ревматизма. АТ к О-стрептолизину
в РСК или РП.– тип иммунного ответа ВТ.
Слайд 42Лечение и профилактика
Лечение антибиотиками (β-лактамы, макролиды).
Стрептококковый бактериофаг.
При скарлатине
ослабленным детям вводят иммуноглобулин.
Профилактика неспецифическая.
Слайд 43Пневмококки
Streptococcus pneumoniae
Может вызывать пневмонии, бронхиты, воспалительные процессы ВДП и пазух
носа, среднего уха, роговицы, сепсис, менингит, эндокардит, артрит и т.д.
Слайд 44Морфология
ланцетовидные диплококки, короткие цепочки;
полисахаридная капсула;
М-протеин иной антигенной специфичности,
чем у S.pyogenes;
неподвижны, спор не образуют.
Слайд 46Культивирование
факультативные анаэробы;
на питательных средах теряют капсулу и переходят из S-
в R-форму;
растут на кровяных и сывороточных средах;
на кровяном агаре
образуют мелкие, точечные колонии, окруженные неполной зоной гемолиза (α-гемолиз); рост на питательных средах угнетается оптохином.
Слайд 47Ферментативные свойства
Расщепляют до кислоты, без газа глюкозу, мальтозу, галактозу и
др.
Оксидазу и каталазу не продуцирует.
Слайд 48Антигенная структура
S.pneumoniae содержит:
∙ поверхностный полисахаридный капсульный АГ;
∙ полисахаридный АГ клеточной стенки (С-полисахарид) – видоспецифический АГ;
∙ М-протеин.
По капсульному АГ – 90 сероваров.
Слайд 49Патогенность
Адгезия – капсульные полисахариды, тейхоевые кислоты и М-белок;
нейраминидаза;
Цитотоксин (пневмолизин);
гемолизины;
ферменты:
пептидаза, расщепляющая IgA, гиалуронидаза, способствующая распространению пневмококка в тканях;
агрессины, подавляющие
фагоцитоз (капсула, протеин М); мурамидаза (лизоцим), подавляющая многие бактерии → колонизация.
Слайд 50Патогенез
Источник – больной, носитель.
Механизмы заражения – аспирационный, контактный.
Путь – воздушно-капельный,
прямой контакт.
Входные ворота – слизистые ВДП.
Инфицирование слизистых респираторного тракта
чаще происходит при нарушении их целостности вирусами (риновирусы, аденовирусы). Пневмококки вызывают бронхиты, пневмонию, реже бактериемию, септицемию и менингит. Генерализованные формы чаще встречаются у маленьких детей и пожилых людей.
Слайд 51Иммунитет
Иммунитет к пневмококковой инфекции типоспецифический.
Реализуется через АТ, фагоцитоз и
комплемента.
Слайд 52Микробиологическая диагностика
Материал: мокрота, смывы с бронхов, плевральная жидкость.
+ ориентировочный.
+ основной.
Количественный: 106
+ биопроба с целью выделения чистой культуры.
+ РНИФ, ИФА.
–.
Слайд 53Лечение и профилактика
Для лечения – антибиотики (β-лактамы, макролиды и др.).
Пневмококки
чувствительны ко многим антибактериальным препаратам, включая пенициллины.
Вакцина разработана, но
ее эффективность и целесообразность применения не бесспорны. Слайд 54Стрептококки группы В
S.agalactia – β-гемолитический стрептококк.
Отличие от S.pyogenes: группоспецифический АГ.
S.agalactia колонизирует слизистую оболочку влагалища, выделяется от 10% здоровых женщин,
а при беременности – до 25%. S.agalactia наиболее опасен для новорожденных (заражаются проходя через инфицированный родовой канал).
Может вызывать послеродовые и урогенитальные инфекции, маститы и вагиниты у женщин, сепсис и менингиты у новорожденных.
Слайд 55Зеленящие стрептококки группы viridans, лишенные группоспецифического антигена
Группа оральных стрептококков (S.mutans,
S. salivarium, S.sanguis, S.oralis и др.).
Отличаются от S.pyogenes образованием мембранотоксина
с α-гемолитической активностью. Продуцируют полисахаридный адгезин, способствующий прилипанию бактерий к сердечным клапанам и зубам.
Могут вызывать стоматологические заболевания, бактериемию, септический эндокардит.
Слайд 56Энтерококки
Family Enterococcaceae
E.faecalis – 80-90%, E.faecium – 10-15%
E.faecalis –
условно-патогенный микроорганизм, имеющий санитарно-показательное значение, является обитателем кишечника человека.
Вызывает
раневую инфекцию, гнойно-воспалительные заболевания желчно-выводящих путей, эндокардиты, перитониты, уроинфекции (чаще всего в ассоциациях с кишечной палочкой, протеем, золотистым стафилококком).E.faecalis может размножаться в пищевых продуктах и вызывает пищевые токсикоинфекции.
Устойчив к антибиотикам.
Слайд 57Грамотрицательные кокки
Основное значение – Neisseria (N.meningitidis и N.gonorrhoeae).
Представители родов
Bronhamella, Moraxella могут вызывать у человека воспалительные процессы.
Acinetobacter –
внутрибольничные инфекции. Слайд 60Менингококки
Neisseria meningitidis
Менингококковая инфекция – острая инфекционная болезнь, характеризующаяся
поражением слизистой оболочки носоглотки, оболочек головного мозга и септицемией; антропоноз.
Слайд 61Морфология
Мелкие (0,6-0,8 мкм) диплококки.
Пара бобовидных клеток, обращенных вогнутыми поверхностями
друг к другу (кофейные зерна).
Неподвижны, спор не образуют, грамотрицательны,
имеют пили, капсула непостоянна.Слайд 62Культивирование
Менингококки – аэробы, обладают цитохромоксидазой и каталазой.
Растут на средах
с сывороткой или кровью барана, лошади, содержащих специальный набор аминокислот,
ристомицин.Повышенная концентрация СО2 в атмосфере стимулирует рост менингококков.
На сывороточном агаре образуют бесцветные нежные колонии вязкой консистенции.
Слайд 64Антигенная структура
По капсульным АГ – серогруппы А, В, С, D
и др.
По АГ клеточной стенки – серовары (1, 2,
3 и т.д.). Во время эпидемических вспышек обычно циркулируют менингококки группы А, они же чаще встречаются при генерализованных формах инфекции. В настоящее время чаще выделяются менингококки серогрупп В и С.
Слайд 65Патогенность
Пили, белки наружной мембраны – адгезия;
капсульные полисахариды –резистентность к фагоцитозу;
нейраминидаза
и гиалуронидаза – инвазия в ткани;
эндотоксин – ЛПС клеточной
стенки, генерализация инфекции, эндотоксический шок. Слайд 66Патогенез
Источник инфекции – больной или носитель (15-20% здоровых носителей).
Механизм
передачи – аспирационный, путь – воздушно-капельный. Встречается преимущественно в зимне-весенний
период.Входные ворота – слизистые ВДП.
Динамика распространения: локальная (назофарингит), генерализованная с прорывом гематоэнцефалического барьера. Гематогенная диссеминация.
Наиболее поражаемые органы – оболочки мозга, мозг (головной, спинной – менингит, менингоэнцефалит), легкие (пневмонии).
Слайд 67Патогенез
Ведущая роль в патогенезе тяжелых форм – инфекционно-токсический шок.
Причины
смерти: острая сердечно-сосудистая недостаточность, отек головного мозга и легких, острая
почечная недостаточность.Летальность при менингококковой инфекции достигает 12,5%.
Слайд 68Иммунитет
Постинфекционный иммунитет при генерализованных формах инфекции стойкий, напряженный.
АТ к
различным АГ клетки (полисахаридам и белкам). Полисахаридные АГ сероваров А
и С обладают высокой иммуногенностью, полисахариды сероваров В почти неимуногенны.АТ от иммунизированной матери могут передаваться плоду трансплацентарным путем и обнаруживаются в течение 2-5 мес. после рождения ребенка.
Слайд 69Микробиологическая диагностика
Материал: кровь, СМЖ, носоглоточные смывы.
+ микроскопия осадка центрифугированной
СМЖ и мазков из зева; при менингококцемии – микроскопия толстой
капли крови.Слайд 70Микробиологическая диагностика
2. + Посев на шоколадный агар, на
агар с ристомицином (или линкомицином), на среду Мартена – агар
с антибиотиками (ВКН – ванкомицин, колистин, нистатин). Идентификация: морфология, Г «–», оксидаза+, серовар. Экспресс-диагностика: определение АГ в СМЖ и ПЦР.3. –
4. + РНГА, ИФА.
5. – Ответ ВТ.
Слайд 71Лечение и профилактика
Антибиотики (пенициллины, левомицетин, рифампицин).
Специфическая профилактика: менингококковая химическая
полисахаридная вакцина по эпидемическим показаниям при эпидемическом подъеме заболеваемости, в
очагах менингококковой инфекции, в группах населения повышенного риска (дети старше 5 лет в организованных коллективах, студенты первых курсов средних и высших учебных заведений, заключенные и др.).Иммуноглобулин человека нормальный вводят детям в возрасте от 6 мес до 7 лет не позднее 7 суток после контакта с больным генерализованной формой менингококковой инфекции.
Слайд 72Возбудитель гонореи
Neisseria gonorrhoeae
Гонорея – инфекционная венерическая болезнь, вызываемая гонококками,
характеризуется гнойным воспалением слизистых оболочек, чаще мочеполовой системы.
Слайд 73Морфология
Гонококк – Г «–» диплококк бобовидной формы, неподвижен; спор не
образует, в организме образует нежную капсулу, имеет пили.
Слайд 74Культивирование
Гонококк – аэроб, требователен к питательным средам.
Применяют сывороточный, асцитический,
кровяной или шоколадный агары.
На асцит-агаре образуют прозрачные колонии с
ровными краями. Оптимальные условия для культивирования: 370С, повышенная концентрация СО2 (5-10%) в атмосфере.
Слайд 76Патогенность
Пили: адгезия, передвижение по слизистой, образование биопленки.
Эндотоксин – ЛПС
клеточной стенки.
Капсулярные полисахариды подавляют фагоцитоз. Характерной особенностью гонококков является их
способность проникать в лейкоциты и размножаться в них.Слайд 77 Патогенез
Источник инфекции – больной человек.
Механизм передачи
– контактный, пути –
половой (гонорея) и
прямой контакт (бленорея). Редко – непрямой контакт (постельное белье, полотенце, мочалка).
Входные ворота – слизистая половых органов, прямой кишки, зева, конъюнктива глаза.
Чаще – локальная инфекция (уретрит, цервицит, поражение шейки матки, придатков у мужчин семенных пузырьков, престательной железы; при экстрагенитальной локализации – повреждение прямой кишки, миндалин, бленорея новорожденных), у лиц со сниженной резистентностью – генерализация процесса (артрит, эндокардит, менингит).
Наиболее поражаемые органы – слизистая, подслизистая мочеполовых путей, конъюнктива, селезенка, костный мозг, печень, суставы (при генерализации).
Бессимптомное течение (у женщин – в 60-80%).
Пути выведения – гнойное отделяемое.
Слайд 78Иммунитет
Иммунитет не формируется (высокая изменчивость, низкая иммуногенность ЛПС).
Организм борется за
счет опсонофагоцитарной реакции и бактерицидной системы сыворотки крови.
В крови
появляются АТ, но они не обладают протективными свойствами. IgA подавляют прикрепление пилей возбудителя к клеткам слизистой уретры, но не могут защитить слизистую от последующего заражения новыми генерациями гонококков с измененной антигенной структурой → реинфекция, рецидивы, хронизация.
Слайд 79Микробиологическая диагностика
+ основной: бактериоскопия препаратов гнойного отделяемого, окрашенного по Граму
или метиленовым синим.
+ при отсутствии результатов микроскопии, особенно при женской
гонореи. РИФ и ПЦР.–
+ при хронической форме.
– ВТ-ответ.
Слайд 80Лечение и профилактика
Лечение – антибиотикотерапия (β-лактамы: цефтриаксон, ципрофлоксацин).
Специфическая профилактика
не разработана.
Экстренная профилактика: местное применение 0,05% раствора биглюконата хлоргексидина;
мерой предупреждения инфицирования является использование презерватива. Для предупреждения бленореи всем новорожденным на конъюнктиву глаза закапывают раствор антибиотика.Вакцина гонококковая предназначен для диагностики (установлении излеченности) гонореи и в качестве вспомогательного метода лечения гонорейной инфекции наряду с другими средствами терапии (больным после безуспешной антибиотикотерапии, при вяло протекающих рецидивах, при хронических формах, мужчинам с осложненной и женщинам с восходящей гонореей, в гинекологической практике при лечении воспалительных процессов).